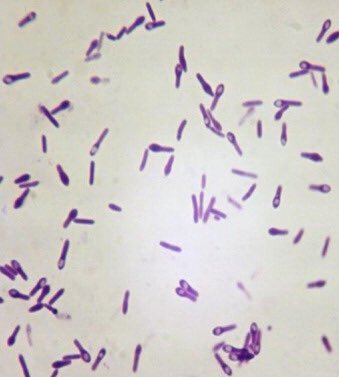

الأبواغ ( الجراثيم ) Spores :
هي عبارة عن أجسام بيضاوية الشكل صغيرة الحجم تتكون عند بعض أنواع البكتيريا في حال تعرضها لظروف قاسية ووظيفتها المقاومة ، فإذا ماتحسنت الظروف تعود الأبواغ ( الجراثيم ) لتتحول إلى خلايا خضرية .
#فريق_الأحياء_التطوعي
#ملتقى_علوم_الأحياء
هي عبارة عن أجسام بيضاوية الشكل صغيرة الحجم تتكون عند بعض أنواع البكتيريا في حال تعرضها لظروف قاسية ووظيفتها المقاومة ، فإذا ماتحسنت الظروف تعود الأبواغ ( الجراثيم ) لتتحول إلى خلايا خضرية .
#فريق_الأحياء_التطوعي
#ملتقى_علوم_الأحياء
بعض أنواع البكتيريا العصوية المستقيمة من جنسي الـ Clostridium , Bacillus تملك القدرة على إنتاج جراثيم داخلية ، جرثومة واحدة بكل خلية ، كما أن بعض انواع البكتيريا الكروية Sporosarcina يمكنها أيضا إنتاج هذا النوع من الجراثيم ،
#الطب_والعلوم_بالعربية
#الطب_والعلوم_بالعربية
أيضا توجد أنواع بكتيرية أخرى كبيرة الحجم نسبيّاً تكون جراثيم داخلية مثل بكتيريا Oscillospira وهي تعيش في أمعاء الحيوانات كالأرانب . كما وجدت جراثيم بكتيريا Metabacterium polyspora في أمعاء حيوانات صغيرة كالفئران والتي تكوّن أكثر من جرثومة في الخلية الواحدة .
وإذا توفرت للجرثومة الظروف المناسبة ستنبت وتكون خلية خضرية ، ولذلك تعتبر الجراثيم الداخلية طور من أطوار دورة الحياة ( وسيلة لحفظ النوع ) وليست وحدة تكاثر .
يتبع
يتبع
البكتيريا المتجرثمة لها القدرة على تحويل نفسها إلى أجسام بيضية أو كروية تعرف بالجراثيم الداخلية Endospores وذلك لوجودها داخل الخلية ، وتتميز هذه الجراثيم بقدرتها الفائقة على كسر الضوء ومقاومتها للصبغ بصبغات الأنيلين القاعدية والتي تصبغ الخلايا الخضرية بسهولة
ولذلك فإن لها طرقاً خاصة بصبغها .
قد تكون الجراثيم الداخلية كروية الشكل كما في بكتيريا Bacillus sphaericus و Clostridium tetani ، أو قد تكون الجرثومة إسطوانية أو عصوية كما في بكتيريا Bacillus anthracis ، أو قد تكون بيضاوية كما في بكتيريا Clostridium botulinum .
يتبع
قد تكون الجراثيم الداخلية كروية الشكل كما في بكتيريا Bacillus sphaericus و Clostridium tetani ، أو قد تكون الجرثومة إسطوانية أو عصوية كما في بكتيريا Bacillus anthracis ، أو قد تكون بيضاوية كما في بكتيريا Clostridium botulinum .
يتبع
للجراثيم الداخلية خواص فسيولوجية مميزة مثل مقاومتها لظروف البيئية غير الملائمة
-كمقاومتها للحرارة العالية
- وبعض الإشعاعات ذات الموجة القصيرة
- والتركيزات المرتفعة نسبيّاً
- والمواد الكيميائية السامة
- وكذلك مقاومتها للجفاف وقدرتها على السكون dormancy لمدة طويلة .
-كمقاومتها للحرارة العالية
- وبعض الإشعاعات ذات الموجة القصيرة
- والتركيزات المرتفعة نسبيّاً
- والمواد الكيميائية السامة
- وكذلك مقاومتها للجفاف وقدرتها على السكون dormancy لمدة طويلة .
بعض الجراثيم الداخلية شديدة المقاومة للحرارة المرتفعة ، فيلزم لتحطيمها حرارة تصل إلى 120 مْ ( بخار تحت ضغط ) لمدة ثلاث ساعات ، إلا ان معظم أنواع الجراثيم تقتل بالحرارة الرطبة عند 115-120 مْ لمدة 15-20 دقيقة .
التركيب الداخلي للجرثومة :
الخلية الجرثومية Germ cell :
تحتوي على سيتوبلازم وعادة تحتوي على كروموسوم واحد وبعض الريبوسومات ويحاط بغشاء داخلي .
جدار الجرثومة spore wall :
يتركب جدار الجرثومة من الميكوببتيد ، وهذا الجدار سيصبح الجدار الخلوي للخلية الخضرية عن الإنبات .
الخلية الجرثومية Germ cell :
تحتوي على سيتوبلازم وعادة تحتوي على كروموسوم واحد وبعض الريبوسومات ويحاط بغشاء داخلي .
جدار الجرثومة spore wall :
يتركب جدار الجرثومة من الميكوببتيد ، وهذا الجدار سيصبح الجدار الخلوي للخلية الخضرية عن الإنبات .
القشرة Cortex :
تكون القشرة نصف حجم الجرثومة تقريبا . وتحتوي على dipicolinat Calcium مختلطة بالـ Micropeptide وهذا الخليط يمكن تحليله بإنزيم Lysozyme . وطبقة القشرة هي التي تمنح الجرثومة المقاومة للحرارة
تكون القشرة نصف حجم الجرثومة تقريبا . وتحتوي على dipicolinat Calcium مختلطة بالـ Micropeptide وهذا الخليط يمكن تحليله بإنزيم Lysozyme . وطبقة القشرة هي التي تمنح الجرثومة المقاومة للحرارة
لاحتوائها على تركيزات عاليه من ملح الكالسيوم بنسبة تتراوح بين 2-5% من الوزن الجاف للجرثومة .
الغشاء الخارجي outer membrane :
الغشاء الخارجي لجرثومة البكتيريا هو غشاء يحيط بالقشرة من الخارج .
الغشاء الخارجي outer membrane :
الغشاء الخارجي لجرثومة البكتيريا هو غشاء يحيط بالقشرة من الخارج .
الغلاف الجرثومي spore coat :
يعطي هذا الغلاف للجرثومة شكلها ، وقد يتكون الغلاف من طبقتين أو ثلاث طبقات ، وهو يحمي الجرثومة من فعل الإنزيمات المحللة .
يعطي هذا الغلاف للجرثومة شكلها ، وقد يتكون الغلاف من طبقتين أو ثلاث طبقات ، وهو يحمي الجرثومة من فعل الإنزيمات المحللة .
الإكسوسبوريم Exosporium :
هي طبقة خارجية تظهر في شكل غشاء رقيق ملاصقا للجرثومة أو غير ملاصقا لها ، وهو غير منفذ لكثير من المركبات ، ويحتوي على بروتين دهني Lipoprotein وسكريات أمينية .
هي طبقة خارجية تظهر في شكل غشاء رقيق ملاصقا للجرثومة أو غير ملاصقا لها ، وهو غير منفذ لكثير من المركبات ، ويحتوي على بروتين دهني Lipoprotein وسكريات أمينية .
Loading suggestions...